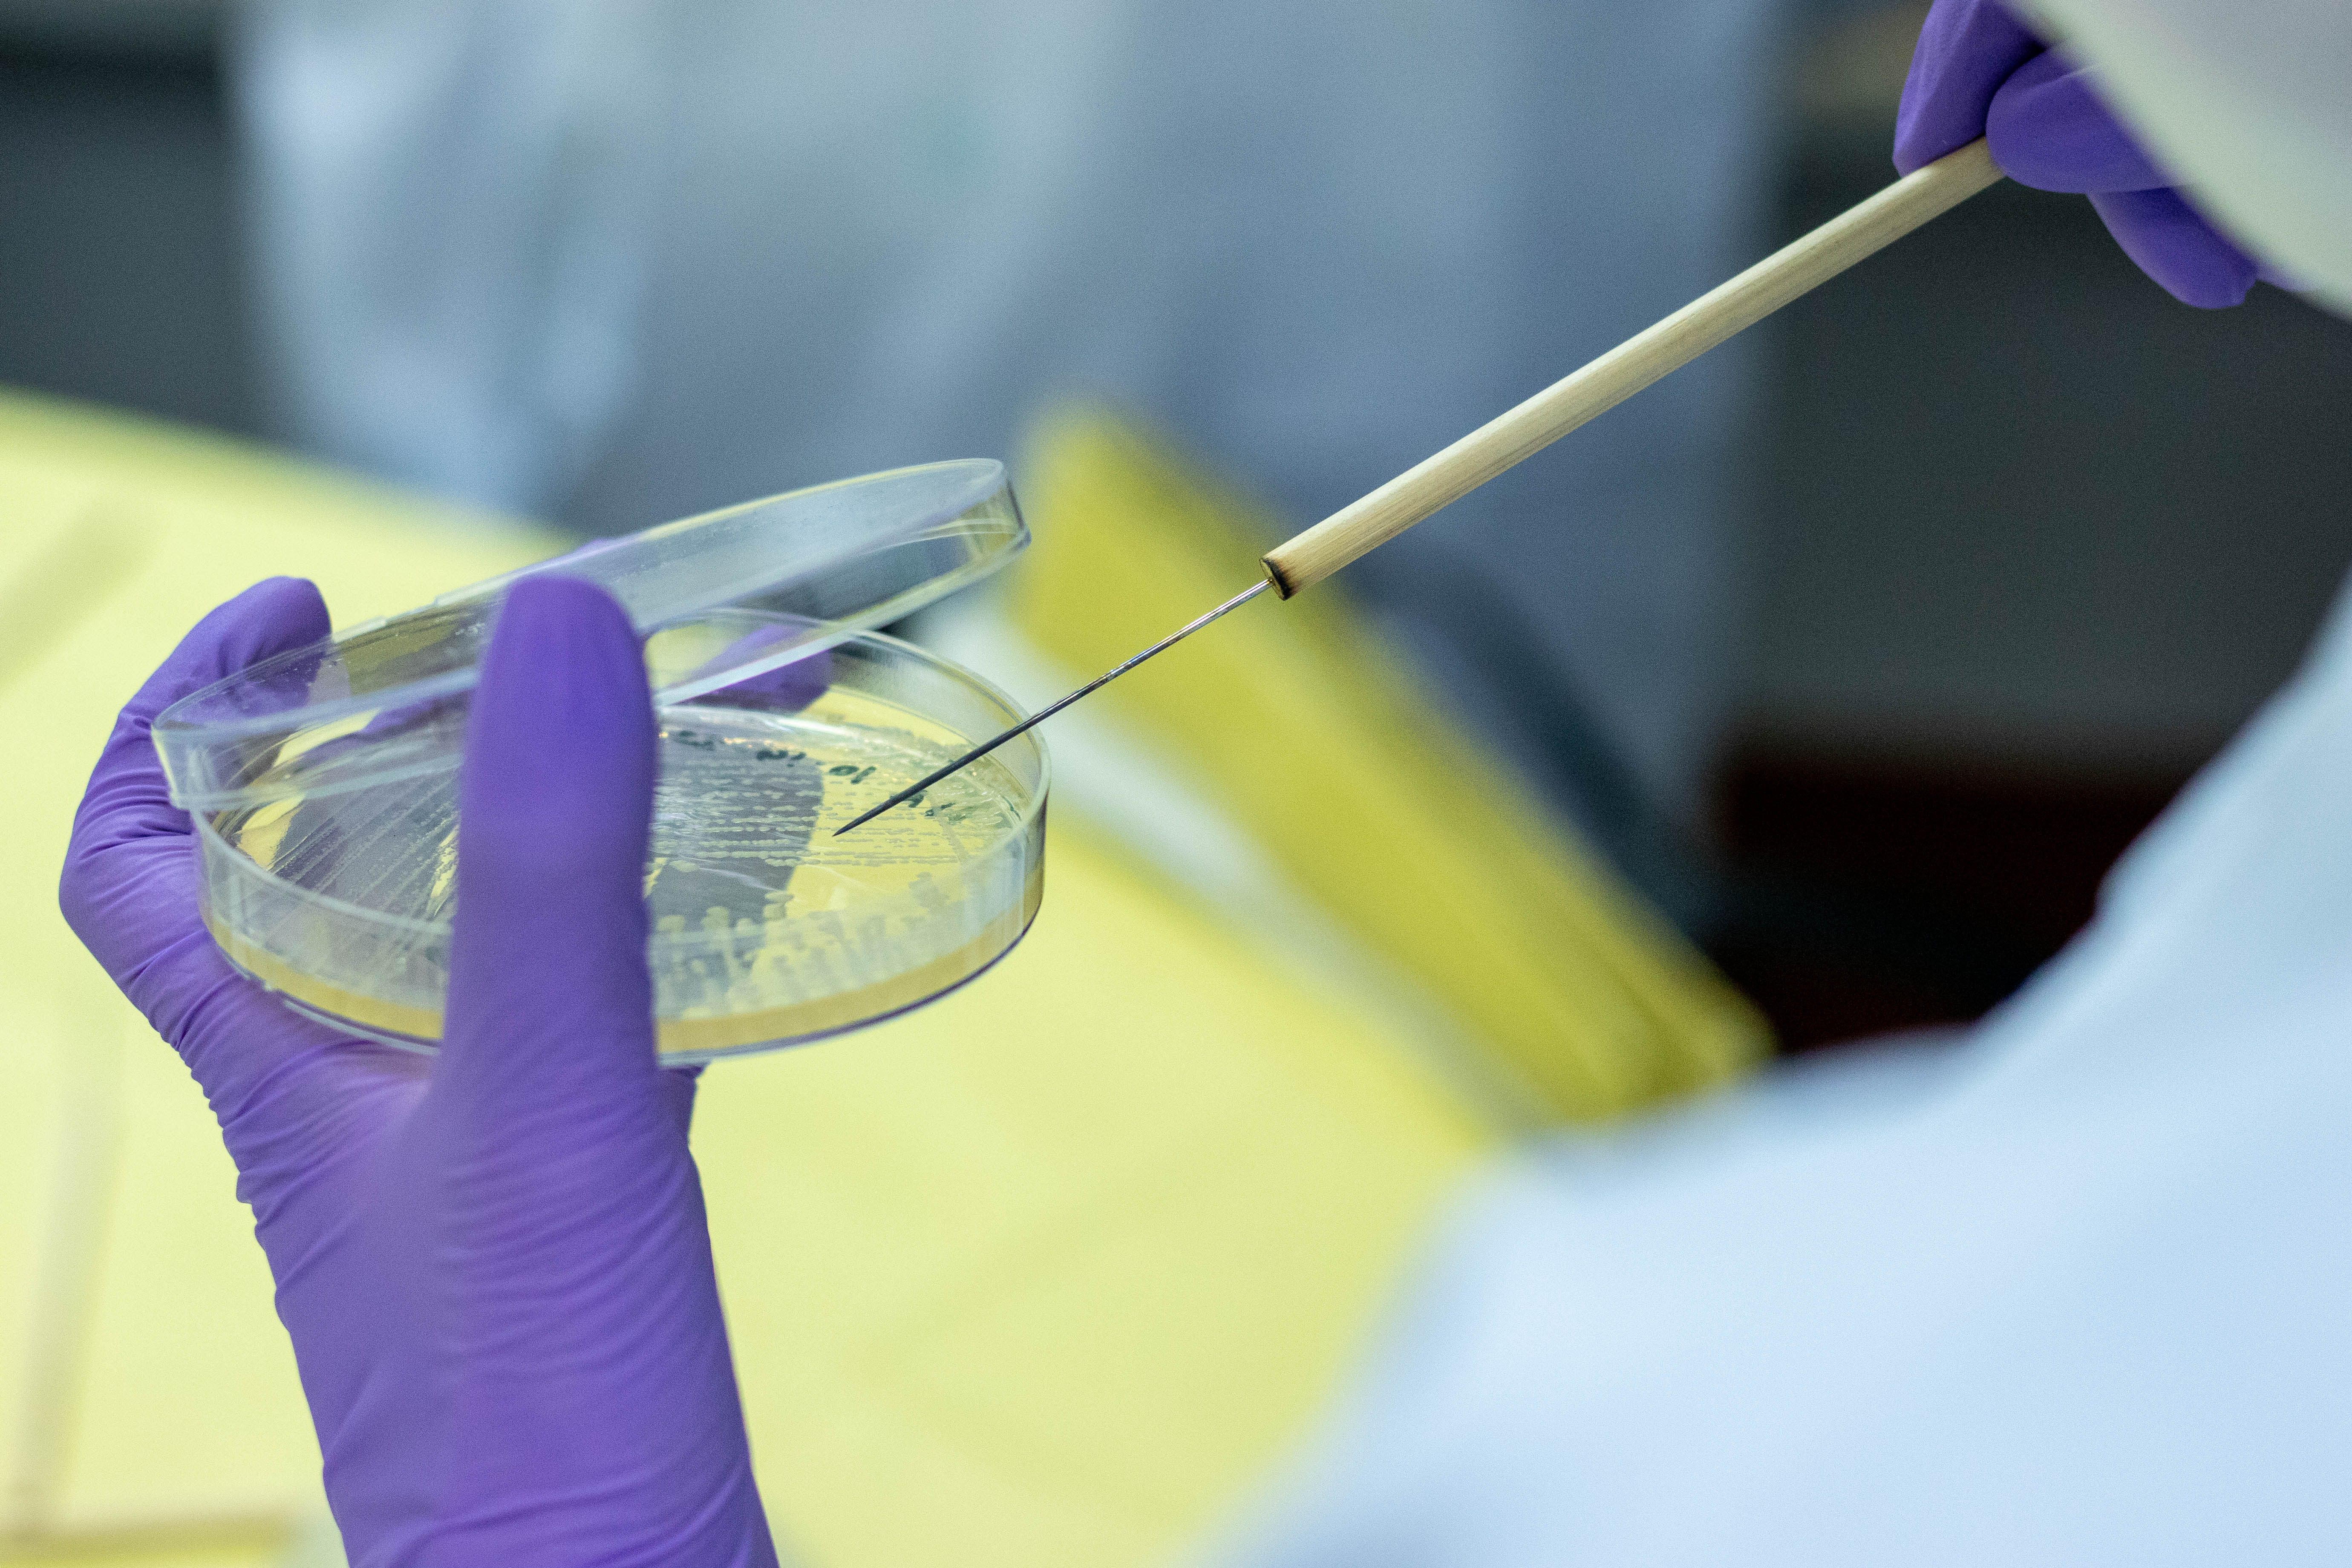

A total of 78 FEU BS Nursing graduates hurdled the November 2019 Nurse Licensure Examination given by the Professional Regulatory Commission. FEU scored a 97.26% rating for first time takers (71/73), while the overall rating finished at 89.66% (78/87).
Kim Paulo Bombio Listor was the lone board placer from FEU at 9th place, as he scored 87.20%.
Performance of Schools
List of successful Examinees who garnered the ten (10) highest places